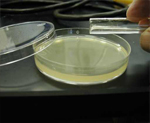
Microbiology

On Microbiology domain the support extended for various services like Bioburden Analysis service, Bacterial endotoxin testing service, Microbial species Identification service (Bacteria, yeast, fungi, Actinomycetes),standard testing methodology in microbial resistance, antimicrobial activity, sterility and limit test.
Microbiology is the study of microorganisms, which are microscopic, unicellular, and cell-cluster organisms.
Evolution of Microbiology
In 1676, Antonie van Leeuwenhoek observed bacteria and other microorganisms, using a single-lens microscope of his own design. While Van Leeuwenhoek is often cited as the first to observe microbes. Robert Hooke made the first recorded microscopic observation, of the fruiting bodies of molds, in 1665. The first observation of microbes using a microscope is generally credited to the Dutch draper and haberdasher, Antonie van Leeuwenhoek, who lived for most of his life in Delft, Holland. It has, however, been suggested that a Jesuit priest called Athanasius Kircher was the first to observe microorganisms. He was among the first to design magic lanterns for projection purposes, so he must have been well acquainted with the properties of lenses. One of his books contains a chapter in Latin, which reads in translation – ‘Concerning the wonderful structure of things in nature, investigated by Microscope. Here, he wrote "who would believe that vinegar and milk abound with an innumerable multitude of worms". He also noted that putrid material is full of innumerable creeping animalculae. These observations antedate Robert Hooke’s Micrographia by nearly 20 years and was published some 29 years before van Leeuwenhoek saw protozoa and 37 years before he described having seen bacteria.
The field of bacteriology (later a sub discipline of microbiology) was founded in the 19th century by Ferdinand Cohn, a botanist whose studies on algae and photosynthetic bacteria led him to describe several bacteria including Bacillus and Beggiatoa. Cohn was also the first to formulate a scheme for the taxonomic classification of bacteria and discover spores. Louis Pasteur and Robert Koch were contemporaries of Cohn’s and are often considered to be the father of Microbiology and medical microbiology, respectively. Pasteur is most famous for his series of experiments designed to disprove the then widely held theory of spontaneous generation, thereby solidifying microbiology’s identity as a biological science. Pasteur also designed methods for food preservation (pasteurization) and vaccines against several diseases such as anthrax, fowl cholera and rabies. Koch is best known for his contributions to the germ theory of disease, proving that specific diseases were caused by specific pathogenic microorganisms. He developed a series of criteria that have become known as the Koch's postulates. Koch was one of the first scientists to focus on the isolation of bacteria in pure culture resulting in his description of several novel bacteria including Mycobacterium tuberculosis, the causative agent of tuberculosis.
Microorganisms are beneficial for microbial biodegradation or bioremediation of domestic, agricultural and industrial wastes and subsurface pollution in soils, sediments and marine environments. The ability of each microorganism to degrade toxic waste depends on the nature of each contaminant. Since sites typically have multiple pollutant types, the most effective approach to microbial biodegradation is to use a mixture of bacterial species and strains, each specific to the biodegradation of one or more types of contaminants.

   
Towards Molecular Biology the service ranges were renowned with the bioassay testing and development, PCR Testing and Mapping, DNA Sequence Analysis, Gel Electrophoresis testing, PCR Amplification, Blotting techniques like Southern and Northern blot, Enzyme inhibition testing, Molecular diagnosis and Restriction enzyme testing.
Molecular Biology is the branch of biology that deals with the molecular basis of biological activity. This field overlaps with other areas of biology and chemistry, particularly genetics and biochemistry. Molecular biology chiefly concerns itself with understanding and the interactions between the various systems of a cell, including the interactions between the different types of DNA, RNA and protein biosynthesis as well as learning how these interactions are regulated.
Since the late 1950s and early 1960s, molecular biologists have learned to characterize, isolate, and manipulate the molecular components of cells and organisms. These components include DNA, the repository of genetic information; RNA, a close relative of DNA whose functions range from serving as a temporary working copy of DNA to actual structural and enzymatic functions as well as a functional and structural part of the translational apparatus; and proteins, the major structural and enzymatic type of molecule in cells.
Bacteria can be used for the industrial production of amino acids. Corynebacterium glutamicum is one of the most important bacterial species with an annual production of more than two million tons of amino acids, mainly L-glutamate and L-lysine. |
|
MicroBiology & Molecular Biology
On Microbiology domain the support extended for various services like Bioburden Analysis service, Bacterial endotoxin testing service, Microbial species Identification service. Read More |
BioInformatics, Molecular Genetics & PharmacoInformatics
Bioinformatics which is the combination of Biological science and Information technology application provides extensive support in service Read More |
Immunology &
Industrial Biotechnology
Bioinformatics which is the combination of Biological science and Information technology application provides extensive support in services Read More |
|
